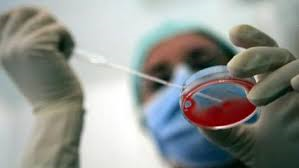

Legge 40: affondata!
 di Maura Cossutta
di Maura Cossutta
La sentenza della Corte Costituzionale ha cancellato il divieto di eterologa previsto dalla legge 40 del 2004. Questa sentenza ha valore di legge e non è oppugnabile. Da oggi cioè non potrà mai più essere votata dal Parlamento una legge che prevede il divieto di fecondazione di tipo eterologa. Un colpo durissimo, definitivo, ad una legge sbagliata, crudele, ideologica, la prima legge confessionale della storia della Repubblica.
Legge contro la quale per ben 30 volte già si erano espresse altre sentenze di Tribunali civili e amministrativi regionali oltre che la Corte Costituzionale, dichiarando illegittimi il divieto di produrre più di 3 embrioni e quello della diagnosi pre impianto. Pezzo dopo pezzo è crollato tutto l’impianto ideologico della legge, fino al colpo finale, questo sull’eterologa.
La Corte ha dichiarato «l’illegittimità costituzionale degli articoli 4, comma 3, 9, commi 1 e 3 e 12, comma 1, della legge 19 febbraio 2004, n. 40, relativi al divieto di fecondazione eterologa medicalmente assistita». Di cosa si parla? Soprattutto di chi?
In sostanza è anticostituzionale la parte della legge in cui si vieta di ricorrere alla donazione di gameti (ovociti o spermatozoi) esterni alla coppia per concepire un figlio. Sull’eterologa la discussione in Parlamento e fuori dal Parlamento è stata fortissima: si sono evocati scenari apocalittici, si è dato vita ad una comunicazione da terrore antropologico, prevedendo un blad runner di casi limite, come quelli di mamme/nonne che hanno guadagnato le prime pagine dei quotidiani. Invece, delle storie quotidiane di migliaia di persone normali nessuno parlava.
Eppure sono tante, tantissime le donne e gli uomini che si ritrovano sterili dopo un percorso di malattia, o dopo una chemioterapia,o dopo l’asportazione delle ovaie, o perché portatori di patologie potenzialmente trasmissibili di tipo infettivo o genetico, o perché ancora troppo giovani con una menopausa precoce.
Sono tutte persone con seri problemi di salute, che fino ad oggi non hanno potuto utilizzare la legge 40 per diventare genitori perché la procreazione assistita omologa per loro era inutile, in quanto i loro gameti non erano utilizzabili. L’unica possibilità fino ad oggi è stata quella di emigrare, cercare all’estero centri in cui si praticasse la fecondazione eterologa.
E infatti sono state più di 4 mila le coppie che ogni anno si sono rivolte a centri esteri, per lo più in Spagna (dove il 63% di trattamenti per fecondazione di gameti è rivolto a coppie italiane) e nei Paesi dell’Est, ma anche a Lugano e in Belgio, pagando un costo variabile tra gli 8 mila euro della Spagna, i 3- 5 mila del Belgio, ai 2 mila euro dei Paesi dell’Est, con l’Ucraina in testa.
Divieti quindi, quelli della legge 40, tanto crudeli quanto inefficaci perché non hanno potuto certo impedire i “viaggi della speranza”. Divieti assurdi, miopi, perché non hanno voluto e saputo prevedere la conseguenza più pericolosa, quella dell’assenza di controlli sull’insorgenza di eventuali infezioni nei genitori e nel neonato, che non vengono seguiti dal nostro Servizio sanitario nazionale, fino all’assenza di dati genetici del bambino nato con le tecniche.
Divieti quindi, quelli della legge 40, tanto crudeli quanto inefficaci perché non hanno potuto certo impedire i “viaggi della speranza”. Divieti assurdi, miopi, perché non hanno voluto e saputo prevedere la conseguenza più pericolosa, quella dell’assenza di controlli sull’insorgenza di eventuali infezioni nei genitori e nel neonato, che non vengono seguiti dal nostro Servizio sanitario nazionale, fino all’assenza di dati genetici del bambino nato con le tecniche.
Divieti ipocriti, perché dietro la rassicurazione di un divieto dentro i nostri confini, si chiudevano gli occhi di fronte al diffondersi ovunque del mercato di gameti. Oggi infatti in tutta Europa e in America non si contano più i siti che pubblicizzano centri per l’acquisto di un seme o di un ovocita, tutto senza controllo.
La decisione della Corte ristabilisce quindi il principio di equità, fra coppie sterili e infertili e il principio della tutela della salute, garantendo un sistema di controlli. L’eterologa sarà possibile, sono mantenute le tutele per i nati dalla tecnica eterologa (cioè il divieto di disconoscimento di paternità), la tecnica sarà gratuita, cioè non bisognerà pagare alcun donatore.
Dopo la sentenza della Corte non serve modificare la legge. Oggi spetta piuttosto al Ministero della Salute, insieme alle società scientifiche e con il supporto delle associazioni di cittadini e pazienti, predisporre un Regolamento e delle Linee Guida per definire il sistema appropriato per la donazione dei gameti. Per esempio – è questa la proposta che più merita attenzione – si potrebbe adottare il modello inglese con l’impiego gratuito dei gameti extranumerari, quelli prodotti con le tecniche omologhe e non utilizzati.
A 10 anni di distanza dalla legge, non serve quindi modificare la legge, quanto piuttosto attuare tutto quello che ancora non è stato attuato. Cosa? Innanzitutto occorre per esempio inserire la procreazione medicalmente assistita tra i Livelli Essenziali di Assistenza (nazionali e non solo in alcune regioni) e includere le tecniche (FIVET e altro) in precise tariffe, prevedendo quindi una tariffa unica nazionale con il relativo ticket, correggere il sistema della mobilità sanitaria tra le varie regioni.
 Senza questo, oggi le coppie del sud non andranno magari all’estero, ma saranno comunque costrette ad emigrare al nord per accedere alle tecniche; la prescrizione dei farmaci per l’infertilità non potrà essere garantita a carico del Servizio sanitario nazionale; nelle regioni continuerà il “regno del fai da te”; i centri pubblici saranno sempre più soffocati dall’offerta del privato; cresceranno i costi inappropriati per la sanità pubblica.
Senza questo, oggi le coppie del sud non andranno magari all’estero, ma saranno comunque costrette ad emigrare al nord per accedere alle tecniche; la prescrizione dei farmaci per l’infertilità non potrà essere garantita a carico del Servizio sanitario nazionale; nelle regioni continuerà il “regno del fai da te”; i centri pubblici saranno sempre più soffocati dall’offerta del privato; cresceranno i costi inappropriati per la sanità pubblica.
A 10 anni di distanza dalla legge, per difendere il diritto di tutte le coppie a poter diventare genitori, è giusto quindi ripartire da qui: da questa sentenza e dalle cose ancora da fare, per garantire che la procreazione assistita possa continuare a essere un ambito della sanità pubblica.
Infine, un’ultima considerazione: questa sentenza è stata possibile solo perché alcune coppie hanno scelto di portare nei Tribunali le loro storie, perché hanno creduto nella Costituzione, utentico faro per i diritti individuali e collettivi, perché non si sono arrese. Nella storia della legge 40, invece, troppo poco si sono ascoltate queste storie: o parlavano i medici o parlavano i preti.
Uno scontro che andava oltre i soggetti, che restavano muti. Oggi hanno vinto innanzitutto loro, ma con loro abbiamo vinto tutti. Impariamo quindi da loro: una lezione per ognuno di noi, di soggettività politica, di impegno civile, di pratica di cittadinanza, di testimonianza dei valori costituzionali.







